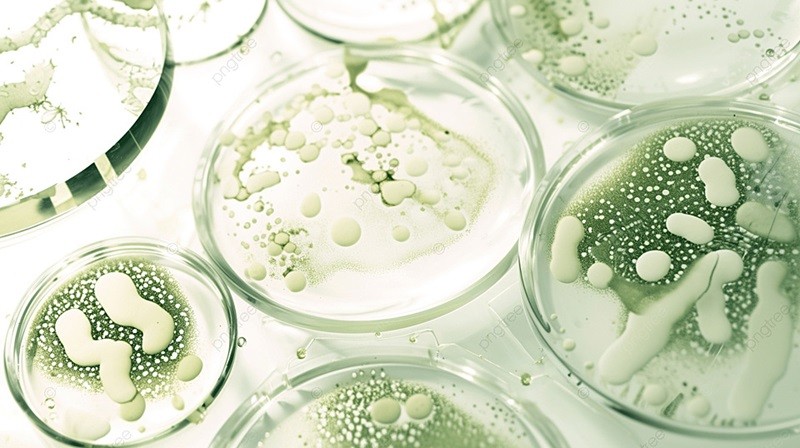
khuan-lac-vi-khuan

Khuẩn lạc là một trong những khái niệm cơ bản nhưng vô cùng quan trọng trong vi sinh học. Việc hiểu rõ về khuẩn lạc, cách phân loại và đếm chúng giúp nghiên cứu, chẩn đoán và sản xuất sinh học trở nên hiệu quả hơn. Hãy cùng tìm hiểu chi tiết về khuẩn lạc trong bài viết dưới đây!
1. Định nghĩa khuẩn lạc
Khuẩn lạc là tập hợp các tế bào vi sinh vật, thường được sinh ra từ một tế bào gốc đơn lẻ trên môi trường nuôi cấy. Các khuẩn lạc này phát triển dần và tạo thành những tập hợp có thể nhìn thấy bằng mắt thường.Khuẩn lạc vi khuẩn và khuẩn lạc nấm có sự khác biệt rõ ràng. Trong khi khuẩn lạc vi khuẩn thường có hình dạng tròn và bề mặt mịn, thì khuẩn lạc nấm, đặc biệt là nấm men, lại có cấu trúc phức tạp hơn, bề mặt xù xì hoặc mượt tùy theo loại.

2. Các loại khuẩn lạc phổ biến
Có nhiều loại khuẩn lạc khác nhau tùy thuộc vào loại vi sinh vật và môi trường nuôi cấy. Dưới đây là một số loại phổ biến:
Khuẩn lạc vi khuẩn: Các ví dụ điển hình bao gồm khuẩn lạc E. coli, Salmonella, và Staphylococcus aureus. Khuẩn lạc vi khuẩn thường có hình dạng nhỏ, tròn và mịn.
Khuẩn lạc vi khuẩn
Khuẩn lạc nấm men và nấm mốc: Nấm men có khuẩn lạc mịn và đều, trong khi khuẩn lạc nấm mốc có thể có bề mặt xù xì và màu sắc đa dạng.

Khuẩn lạc nấm men
Khuẩn lạc dạng S, R, M:
– Dạng S có bề mặt mịn, bóng và tròn đều.
– Dạng R có bề mặt gồ ghề, không đều.
– Dạng M thường có cấu trúc đám, không rõ hình dạng.
Khuẩn lạc xạ khuẩn: Nhóm vi sinh vật này thường có khuẩn lạc phức tạp, ứng dụng phổ biến trong nghiên cứu và phát triển kháng sinh.
3. Đặc điểm hình thái của một số khuẩn lạc
Các khuẩn lạc khác nhau sẽ có những đặc điểm hình thái riêng biệt, giúp nhận diện chúng dễ dàng hơn:
Khuẩn lạc dạng S: Bề mặt mịn màng, bóng và có viền đều. Đây là dạng phổ biến ở nhiều loại vi khuẩn như Streptococcus.
Khuẩn lạc dạng R: Có bề mặt gồ ghề và viền không đồng đều. Khuẩn lạc dạng này thường xuất hiện ở các loại vi khuẩn gây bệnh lao.
Khuẩn lạc Bacillus subtilis: Hình thái đặc trưng với bề mặt gồ ghề, cấu trúc không đều, dễ dàng nhận biết trong môi trường nuôi cấy.
Khuẩn lạc Salmonella trên môi trường XLD: Thường có màu đen hoặc đỏ, giúp phân biệt với các loại khuẩn lạc khác trong nghiên cứu.
4. Khuẩn lạc trong nghiên cứu và ứng dụng
Trong nghiên cứu vi sinh học, khuẩn lạc đóng vai trò quan trọng trong việc xác định và phân loại vi khuẩn hoặc nấm. Một số ví dụ tiêu biểu:
Khuẩn lạc Vibrio parahaemolyticus: Vi khuẩn gây bệnh đường ruột, được phát hiện qua các đặc điểm hình thái khuẩn lạc.
Khuẩn lạc Staphylococcus aureus: Vi khuẩn gây nhiễm trùng da và viêm phổi.
Khuẩn lạc Bacillus: Một trong những loại vi khuẩn có ứng dụng trong sản xuất enzyme và thuốc kháng sinh.
Khuẩn lạc E. coli: Thường được sử dụng trong nghiên cứu thực phẩm và y học để kiểm tra mức độ an toàn.
Các khuẩn lạc này không chỉ giúp xác định loại vi khuẩn, mà còn được dùng để phát triển kháng sinh, phân lập vi sinh vật có lợi.
5. Đơn vị tính khuẩn lạc
Trong vi sinh học, khuẩn lạc thường được tính bằng hai đơn vị chính:
CFU (Colony Forming Units): Đơn vị biểu thị số khuẩn lạc có khả năng sinh trưởng và tạo ra một khuẩn lạc rõ rệt.
MPN (Most Probable Number): Đơn vị đo lường số lượng vi khuẩn dựa trên xác suất, thường được sử dụng trong kiểm tra nguồn nước.
Phân biệt CFU và MPN: CFU (Colony Forming Units) là đơn vị đo số khuẩn lạc có khả năng hình thành từ một mẫu thử nhất định. CFU thường được tính bằng phương pháp đổ đĩa hoặc cấy trải, nơi vi khuẩn phát triển trên môi trường đặc như thạch, và các khuẩn lạc được đếm thủ công bằng mắt thường hoặc qua công nghệ hiện đại.
Trong khi đó, MPN (Most Probable Number) được tính bằng phương pháp lên men, với mẫu được nuôi cấy trong môi trường lỏng. Thay vì đếm trực tiếp, kết quả MPN được so sánh với bảng xác suất.
Mặc dù MPN và CFU có cách tiếp cận khác nhau, cả hai đều tương đương và được các tổ chức khoa học và quản lý trên thế giới công nhận, bao gồm Cơ quan Bảo vệ Môi trường Hoa Kỳ (EPA) và Tổ chức Tiêu chuẩn hóa Quốc tế (ISO).
6. Phương pháp đếm và quan sát khuẩn lạc
Để đếm khuẩn lạc chính xác, người ta sử dụng phương pháp thủ công hoặc thiết bị tự động:
Đếm trên đĩa Petri: Phương pháp truyền thống, quan sát số lượng khuẩn lạc trực tiếp bằng mắt thường.
Máy đếm khuẩn lạc Funke Gerber: Thiết bị tự động giúp tăng tính chính xác và hiệu quả trong việc đếm khuẩn lạc.

Máy đếm khuẩn lạc Funke Gerber
Máy đếm khuẩn lạc tự động: Giúp tiết kiệm thời gian và đảm bảo độ chính xác cao trong phòng thí nghiệm.
7. Địa chỉ mua máy móc thiết bị và hóa chất phòng thí nghiệm uy tín
Nếu bạn đang tìm kiếm địa chỉ uy tín để mua máy móc và hóa chất phòng thí nghiệm, Vietchem là lựa chọn hàng đầu với các sản phẩm chất lượng, dịch vụ chuyên nghiệp và giá cả cạnh tranh.
Khi mua hàng tại VietChem, bạn sẽ có những trải nghiệm mua sắm thông minh và vô cùng tuyệt vời.
– Được tư vấn hỗ trợ 24/7 để lựa chọn được sản phẩm phù hợp nhất với công việc và chi tiêu.
– Thủ tục đặt mua hàng và thanh toán nhanh gọn, đơn giản.
– Được đảm bảo giao hàng tận tay trong thời gian nhanh chóng.
– Kiểm tra hàng trước khi nhận.
– Chính sách lắp đặt, bảo hành đảm bảo.
Liên hệ ngay qua Hotline 0826 020 020 để được tư vấn và hỗ trợ
Khuẩn lạc là khái niệm quan trọng trong vi sinh học, có vai trò lớn trong nghiên cứu, y học và công nghệ thực phẩm. Hiểu rõ về các loại khuẩn lạc, cách đếm và phân loại giúp tăng hiệu quả trong các nghiên cứu và ứng dụng thực tiễn.
8. Câu hỏi thường gặp (FAQ)
Khuẩn lạc là gì?Khuẩn lạc là tập hợp tế bào vi sinh vật sinh ra từ một tế bào đơn lẻ trên môi trường nuôi cấy.
Khuẩn lạc vi khuẩn có đặc điểm gì?Khuẩn lạc vi khuẩn thường nhỏ, tròn, và có bề mặt mịn hoặc gồ ghề tùy thuộc vào loại vi khuẩn.
Làm thế nào để phân biệt khuẩn lạc của các loại vi khuẩn khác nhau?Việc phân biệt khuẩn lạc dựa vào hình thái, màu sắc, và môi trường nuôi cấy của chúng.
